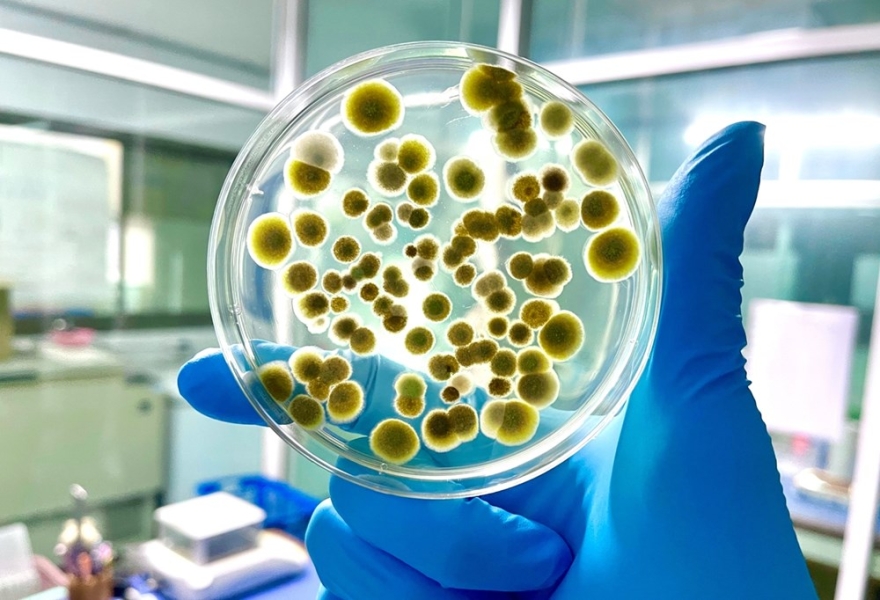

دور المثبطات والبلازما الغنيه بالصفائح في علاج الثعلبه
ثعلبه الراس تبقى واحده من اكثر امراض فروه الراس تاثيرا على نفس المريض، اذ ترتبط مباشره بمظهر الشخص وثقته بنفسه، ويبحث كثير من المرضى عن علاج ثعلبه فعال يعيد الشعر ويوقف التدهور، خصوصا مع تنوع العلاجات الحديثه بين المثبطات المناعيه وتقنيه البلازما الغنيه بالصفائح التي انتشرت بشكل واسع.
وقال البروفيسور رودني سنكلير استاذ الجلديه في جامعه ملبورن ان الثعلبه لا يمكن التعامل معها كحاله تجميليه بسيطه، موضحا ان اضطراب المناعه في بصيلات الشعر يلعب دورا مركزيا، ومضيفا ان الجمع بين مثبطات مناسبه وتقنيه بلازما غنيه بالصفائح يعطي نتائج مبشره اذا تم تطبيقهما ضمن بروتوكول علاجي دقيق.
واكد البروفيسور جيري شابيرو الخبير العالمي في مركز شيكاغو لامراض الشعر ان علاج ثعلبه لم يعد يعتمد على دواء واحد كما كان في السابق، مبينا ان فهم طبيعه الالتهاب المناعي في بصيله الشعر ومعرفه دوره في تساقط الشعر يجعل الخيارات العلاجيه اكثر دقه، خصوصا عند استخدام مثبطات حديثه مع البلازما الغنيه بالصفائح للحصول على استجابه اسرع.
ونوه سنكلير الى ان المثبطات المناعيه المستخدمه في علاج الثعلبه ليست شيئا جديدا، الا ان تطور مثبطات مسار جاك خلال العقد الاخير غيّر شكل العلاج، مشيرا الى دراسات عالميه اثبتت ان مثبطات جاك قد تعيد نمو الشعر عند نسبه جيده من المرضى خصوصا في حالات ثعلبه الراس المنتشره التي تفشل فيها العلاجات التقليديه.
وبين شابيرو ان البلازما الغنيه بالصفائح تقدم دعما علاجيا مهما، اذ تعمل على تحفيز نمو الشعر وتنشيط الدوره الدمويه في فروه الراس، وموضحا ان استخدامها مع مثبطات محدده يقدم فرصه حقيقيه لوقف تقدم الثعلبه واعاده الشعر بشكل تدريجي خلال اشهر اذا تم الالتزام بالجلسات والجرعات المقرره.
تحليل علمي لاليات الثعلبه
تقدم دراسه منشوره في مجله ديرماتولوجي اندوكرينولوجي امريكيه عام ٢٠٢٠ تفاصيل موسعه حول الاليه المناعيه لتطور الثعلبه، حيث اظهرت ان الخلايا التائيه السامه تهاجم البصيلات الساكنه وتدفعها للدخول في حاله توقف، بينما تساهم مواد التهابيّه في منع عوده الشعر للنمو مره اخرى.
وقال سنكلير ان هذه الاليه تجعل علاج ثعلبه يعتمد على خط دفاع مزدوج، خط يستهدف التفاعل المناعي عبر مثبطات متخصصه، وخط اخر يوفر بيئه صالحه لنمو الشعر عبر البلازما الغنيه بالصفائح، مضيفا ان الدمج بينهما يعطي فرصه واقعيه لاعاده التوازن البيولوجي في فروه الراس خلال فتره زمنيه اقصر.
واكد شابيرو ان وجود التهاب مناعي عميق داخل البصيله يفسر سبب عدم نجاح بعض العلاجات التقليديه التي تركز فقط على تنشيط فروه الراس، مبينا ان علاج الثعلبه يحتاج لدواء قادر على تعطيل مسار الالتهاب نفسه، وهي مهمه تقوم بها المثبطات الحديثه خصوصا مثبطات جاك ذات الفعاليه المثبته.
ونوهت دراسه منشوره في مجله جورنال اوف كلينيكال ديرماتولوجي عام ٢٠٢٢ الى ان البلازما الغنيه بالصفائح تحتوي على بروتينات تحفيزيه قادره على اعاده تشغيل الخلايا الجذعيه داخل بصيله الشعر، موضحه ان حقنها بشكل دوري يزيد من سماكه الشعر ويحسن نشاط البصيله حتى في مناطق تعاني من ثعلبه متوسطه الى شديده.
وبين الباحثون في الدراسه ان الجمع بين مثبطات جاك والبلازما الغنيه بالصفائح اسهم في رفع نسبه الاستجابه لدى المرضى، خصوصا خلال الاشهر الاولى من العلاج، وموضحين ان البروتوكول المزدوج ينجح في ايقاف التدهور اولا ثم يتدرج في اعاده نمو الشعر بنسب تختلف حسب شده الثعلبه وامتدادها.
المثبطات المناعيه ودورها العلاجي
يعتبر استخدام مثبطات جاك واحدا من اكثر التطورات بروزا في علاج ثعلبه الراس، اذ تعتمد هذه الادويه على تعطيل اشارات مناعيه معينه تمنع نمو الشعر، وقد اظهرت تجارب دوليه تقدم ملحوظ لدى مرضى عانوا لسنوات من فشل علاجات سابقه.
وقال سنكلير ان مثبطات جاك مثل توفاسيتينيب وروكسوليتينيب قدمت ادله قويه على فعاليتها، مضيفا ان هذه الادويه تسمح للبصيله بالعوده تدريجيا لدورها الطبيعي، ومبينا ان نجاح العلاج يعتمد على مده المرض وعمر المريض ووجود امراض مناعيه مرافقه.
واكد شابيرو ان المثبطات ليست علاجا سحريا كما يعتقد البعض، موضحا انها تحتاج فتره لا تقل عن ثلاثه الى سته اشهر لظهور نتائج واضحه، ومبينا ان استخدامها دون اشراف متخصص قد يؤدي لنتائج ضعيفه، خصوصا اذا لم يتم تحديد جرعه دقيقه تتناسب مع درجه ثعلبه المريض.
ونوه سنكلير الى ان مثبطات جاك لا تعمل بمفردها دائما، حيث تكون فعاليتها اعلى عند دعمها بعلاج يساعد فروه الراس على التأهيل الحيوي، مثل جلسات البلازما الغنيه بالصفائح التي تنشط محيط البصيله وتعزز النمو الجديد، ما يجعل نتيجه علاج الثعلبه اكثر ثباتا واستمرارا.
وبين شابيرو ان الجمع بين العلاجين لا يعني استخدامهما عشوائيا، بل ضمن جدول علاجي ثابت، موضحا ان المثبطات تعمل على تهدئه المناعه بينما تقوم البلازما الغنيه بالصفائح بتنشيط النمو، ومؤكدا ان هذا التناسق يوفر مسارا متكاملا للتعامل مع الثعلبه خصوصا في الحالات المتوسطه والشديده.
البلازما الغنيه بالصفائح وتقويه نمو الشعر
تشير دراسه منشوره في مجله ديرماتولوجيك سيرجري عام ٢٠١٨ الى ان البلازما الغنيه بالصفائح استطاعت تحسين كثافه الشعر لدى مرضى ثعلبه الراس الخفيفه والمتوسطه بنسب ملحوظه خلال سته اشهر، اذ اسهمت في تحفيز الخلايا الجذعيه وتسريع نمو الشعيرات الجديده.
وقال سنكلير ان البلازما الغنيه بالصفائح لعبت دورا متزايدا خلال السنوات الاخيره، موضحا انها توفر مواد غذائيه تساهم في اعاده تنشيط البصيلات التي دخلت مرحله خمول طويل، ومبينا ان دمجها مع مثبطات مناعيه موجهه اعطى نتائج افضل خصوصا لدى المرضى الذين يعانون من فقدان شعر شديد.
واكد شابيرو ان البلازما ليست مجرد جلسات تجميليه كما يتصور البعض، بل تدخل ضمن بروتوكول علاجي علمي يستهدف اعاده بناء البيئه الحيويه للبصيله، مبينا ان فعاليتها ترتبط بانتظام الجلسات، وجوده الاستخلاص، وعدد الصفائح المستخدمه في عمليه الحقن.
ونوه سنكلير الى ان البلازما الغنيه بالصفائح لا تصلح لجميع حالات الثعلبه، موضحا ان المرضى الذين يعانون من التهاب مناعي مرتفع لن يستفيدوا بالشكل الكافي ما لم يتم استعمال مثبطات تتحكم بالالتهاب، ومبينا ان الدمج بين العلاجين يحقق توازنا اساسيا في نمو الشعر.
وبين شابيرو ان نتائج البلازما تظهر تدريجيا، اذ تعود البصيلات للنشاط على مراحل، ما يجعل التجربه العلاجيه في علاج الثعلبه اكثر واقعيه وتدرجا، خصوصا لدى المرضى الذين يعانون من بقع محدوده او تساقط متقطع ومتكرر.
التكامل العلاجي بين المثبطات والبلازما الغنيه بالصفائح في علاج الثعلبه
تطور فهم علاج الثعلبه خلال العقد الاخير بعد ظهور ادله علميه قويه تؤكد ان الجمع بين اكثر من علاج يرفع فرص الاستجابه، خصوصا عند دمج مثبطات المناعه مع جلسات البلازما الغنيه بالصفائح، ويشير متخصصون عالميون الى ان هذا الدمج يقدم معامله حقيقيه لخفض الالتهاب واعاده تشغيل البصيله بشكل متوازن.
وقال البروفيسور رودني سنكلير ان المثبطات وحدها قد توقف تساقط الشعر لكنها لا توفر الدعم الحيوي الذي تحتاجه البصيله لاستعاده قوتها، موضحا ان البلازما الغنيه بالصفائح تكمل الجانب البيولوجي عبر تنشيط محيط البصيله، ومضيفا ان هذا التكامل يعد واحدا من افضل مسارات علاج الثعلبه.
واكد البروفيسور جيري شابيرو ان ادويه مثبطات جاك تقطع الاشاره المناعيه المسببه لتوقف البصيله، مبينا ان البلازما الغنيه بالصفائح توفر وسطا غنيا بعوامل النمو التي تعيد للبصيله توازنها الطبيعي، ومتحدثا عن اهميه جدول العلاج المنتظم الذي يحدد دقه الجلسات وتوقيت الجرعات لضمان نجاح علاج الثعلبه.
ونوه سنكلير الى ان البروتوكولات المزدوجه لا تناسب جميع الحالات، موضحا ان بعض المرضى يحتاجون الى فتره تحضير قبل البدء بالعلاج، مثل تنظيف فروه الراس ومعالجه الالتهابات السطحيه، ومشيرا الى ان التقييم الاولي يعد اساسيا لتحديد عدد جلسات البلازما والغرض من استخدام المثبطات.
وبين شابيرو ان علاج الثعلبه يحتاج خطه طويله المدى، اذ يتطلب استمرار المثبطات لعده اشهر قبل ظهور نتائج ملموسه، بينما تحتاج البلازما الغنيه بالصفائح لعده جلسات متتاليه حتى تحقق تحسنا في الكثافه، مؤكدا ان الالتزام هو العامل الاكثر تاثيرا على نجاح البروتوكول العلاجي.
تاثير المثبطات على البيئه المناعيه للبصيله
تعتمد فعاليه المثبطات في علاج الثعلبه على قدرتها في تعطيل المسار الالتهابي الذي يهاجم بصيله الشعر، وتظهر الابحاث ان مثبطات جاك تستهدف نقاط تحكم دقيقه داخل الخلايا المناعيه، ما يساعد البصيله على الخروج من مرحله التوقف واستعاده دورتها الطبيعيه خلال اسابيع الى اشهر.
وقال سنكلير ان مسار جاك يشكل واحدا من اهم المسارات المناعيه المتورطه في الثعلبه، موضحا ان تعطيل هذا المسار يتيح للشعر فرصه للنمو من جديد، ومضيفا ان فاعليه المثبطات تعتمد على الاستجابه المناعيه لكل مريض، مما يجعل تقييم الحاله عاملا محوريا قبل البدء بالعلاج.
واكد شابيرو ان المثبطات ليست متشابهه في تاثيرها، مبينا ان بعض انواعها يعمل بشكل موجه على الخلايا المناعيه التي تسبب الالتهاب، بينما يقدم بعضها استجابه اوسع، وموضحا ان اختيار الدواء المناسب يحتاج لخبره سريريه دقيقه خصوصا في حالات الثعلبه الشامله او الثعلبه المناعيه النشطه.
ونوه سنكلير الى ان المثبطات قد تبطئ تساقط الشعر خلال الاسابيع الاولى، لكنها تحتاج فتره اطول حتى تعيد انبات شعر قوي في المناطق المصابه، مشيرا الى ان هذه الفتره يجب ان تترافق مع جلسات البلازما الغنيه بالصفائح لتحقيق نمو اسرع واكثر ثباتا، خصوصا في حالات الثعلبه المعقده.
وبين شابيرو ان المهم ليس فقط نمو الشعر بل ثباته بعد الانبات، مؤكدا ان الدمج بين المثبطات والبلازما الغنيه بالصفائح ادى في تجارب كثيره الى نتائج افضل على المدى الطويل، ومبينا ان هذا النموذج العلاجي يمثل الاتجاه العالمي الجديد في علاج الثعلبه.
دور البلازما الغنيه بالصفائح في اصلاح بصيله الشعر
تقدم البلازما الغنيه بالصفائح عوامل نمو تساهم في علاج الثعلبه عبر تحسين الترويه الدمويه للبصيله وتحفيز الخلايا الجذعيه، وقد اكدت دراسه منشوره في مجله ديرماتولوجيك سيرجري عام ٢٠١٨ ان هذه التقنيه رفعت كثافه الشعر لدى كثير من المرضى خلال اشهر قليله.
وقال سنكلير ان البلازما الغنيه بالصفائح تعمل بشكل مزدوج، جزء يعيد تنشيط الخلايا الجذعيه داخل البصيله، وجزء اخر يحسن الوسط الحيوي حولها، موضحا ان الجلسات المتتابعه ترفع فرص نجاح علاج الثعلبه خصوصا اذا كانت البصيله ما زالت قابله للاستجابه الحيويه.
واكد شابيرو ان البلازما ليست علاجا سريعا كما يعتقد البعض، مبينا ان نتائجها تظهر تدريجيا مع تراكم الجلسات، ومشيرا الى ان فعاليتها ترتفع بشكل ملحوظ عندما تستخدم بجانب المثبطات التي تقلل الالتهاب المناعي، مما يمنح البصيله مناخا افضل للنمو واستعاده وظيفتها الطبيعيه.
ونوه سنكلير الى ان البلازما الغنيه بالصفائح لا تساعد فقط في اعاده نمو الشعر، بل تساهم في تقليل الترقق وزياده سماكه الشعيرات الموجوده، وموضحا ان هذا الاثر مهم في علاج الثعلبه لانه يمنح المريض تحسنا بصريا واضحا حتى قبل اكتمال عمليه الانبات الكامله.
وبين شابيرو ان اختيار عدد الجلسات يعتمد على شده الثعلبه، مؤكدا ان المرضى الذين يملكون بقعا صغيره يحتاجون جلسات اقل من الذين يعانون من توسع المرض، ومبينا ان خطه العلاج يجب ان تكون مرنه وتخضع لاعاده تقييم كل شهرين لضمان تحقيق افضل نتيجه ممكنه.
الارتباط بين الالتهاب العميق والثعلبه المقاومه
توضح دراسه منشوره في مجله ديرماتولوجي اندوكرينولوجي عام ٢٠٢٠ وجود دور مركزي للالتهاب العميق في استمرار تساقط الشعر لدى مرضى الثعلبه، اذ يهاجم جهاز المناعه البصيله ويمنعها من الدخول في مرحله النمو، ما يجعل كثير من العلاجات السطحيه غير فعاله بدون مثبطات توجه هذا الالتهاب.
وقال سنكلير ان فهم هذه الاليه غيّر تماما طريقه علاج الثعلبه، موضحا ان اي بروتوكول يعتمد فقط على تنشيط فروه الراس سيكون محدود الفائده، ومضيفا ان التوازن الحقيقي يتحقق عندما يتم ايقاف الالتهاب ثم تفعيل البصيله عبر البلازما الغنيه بالصفائح.
واكد شابيرو ان الثعلبه المقاومه ترتبط بوجود التهاب مناعي نشط، مبينا ان مثبطات جاك تقدم فرصه لتقليل هذا النشاط، وموضحا ان المرضى الذين استفادوا من العلاج المزدوج كانوا اكثر قدره على الحفاظ على نتائج علاج الثعلبه لفترات طويله دون انتكاس متكرر.
ونوه سنكلير الى ان الالتهاب العميق قد لا يظهر دائما على شكل احمرار في فروه الراس، ما يجعل التشخيص السريري اكثر تعقيدا، ومشيرا الى ان بعض الحالات تحتاج فحصا دقيقا للبصيله عبر الاجهزه الضوئيه قبل اختيار العلاج المناسب.
وبين شابيرو ان الثعلبه ليست حاله ثابته بل تمر بموجات من النشاط والهدوء، مؤكدا ان المثبطات تمنح المريض قدره على التحكم بهذه الموجات، بينما توفر البلازما الغنيه بالصفائح دعما بنيويا يعزز السماكه ويمنع الترقق الذي قد يعود بسرعه اذا توقف العلاج المناعي.
هل الدمج بين العلاجين مناسب لجميع حالات الثعلبه؟
يعتقد كثير من المرضى ان الدمج بين مثبطات جاك والبلازما الغنيه بالصفائح يناسب كل الحالات، لكن الخبراء يشيرون الى ان علاج الثعلبه يحتاج تقييما دقيقا قبل اعتماد هذا البروتوكول، اذ تختلف استجابه البصيله حسب العمر ومده المرض ونوع الثعلبه وعمق الالتهاب المناعي.
وقال سنكلير ان بعض المرضى يحققون نتائج ممتازه باستخدام المثبطات فقط دون البلازما، خصوصا عندما تكون الثعلبه منتشره بشكل واسع، موضحا ان البصيله في هذه الحالات تحتاج اولا الى تهدئه الالتهاب ثم يتم تقييم الحاجه لجلسات البلازما لاحقا حسب سرعه الاستجابه.
واكد شابيرو ان بعض حالات الثعلبه الخفيفه او البقعيه تستجيب للبلازما وحدها، مبينا ان هذه الفئه من المرضى تمتلك قدره اكبر على استجابه الخلايا الجذعيه، وموضحا ان اضافه المثبطات في هذه الحالات قد لا تكون ضروريه الا اذا ظهرت علامات نشاط مناعي مرتفع.
ونوه سنكلير الى ان الحالات المزمنه تحتاج بروتوكولا مزدوجا اكثر صرامه، حيث يكون الالتهاب المناعي قد استقر داخل البصيله لفتره طويله، ومشيرا الى ان الدمج بين المثبطات والبلازما الغنيه بالصفائح يكون الحل الافضل لاعاده تشغيل البصيله بشكل تدريجي دون ضغط علاجي زائد.
وبين شابيرو ان علاج الثعلبه ليس وصفه جاهزه بل خطه متكامله، مؤكدا ان نجاح العلاج يعتمد على دقه التشخيص، واستمرار المتابعه، وتطبيق خطوات ثابتة تشمل التحكم بالمناعه وتنشيط البصيله، ومبينا ان هذا النهج اصبح معيارا عالميا في المراكز المتخصصه.
البروتوكولات المتقدمه لدمج المثبطات والبلازما الغنيه بالصفائح في علاج الثعلبه
يعتبر الدمج بين المثبطات والبلازما الغنيه بالصفائح مسارا علاجيا متقدما يعتمد على فهم بيولوجيا البصيله ومسارات المناعه، وقد اكد متخصصون في الامراض الجلديه ان هذا الدمج يمثل مرحله جديده في علاج الثعلبه لانه يتعامل مع جذور المشكله ويستهدف توقف الدوره الحيويه للشعر بشكل مباشر ودقيق.
وقال سنكلير ان نجاح اي بروتوكول يعتمد على التوقيت الصحيح، موضحا ان المثبطات يجب ان تبدأ في وقت مبكر لوقف الهجوم المناعي، ومضيفا ان جلسات البلازما الغنيه بالصفائح يجب ان تتزامن مع بداية الاستقرار المناعي لتعزيز الاستجابه، ومؤكدا ان هذا الدمج يرفع فرص علاج الثعلبه بنسب كبيره.
واكد شابيرو ان الدمج بين العلاجات يقدم مسارا اكثر شمولا، مبينا ان المثبطات وحدها قد توقف تساقط الشعر لكنها لا تعيد بناء البصيله، بينما تقدم البلازما عوامل نمو تعالج التلف البنيوي، وموضحا ان هذا التوازن العلاجي هو ما يجعل النتائج اكثر ثباتا عند مرضى الثعلبه المقاومه.
ونوه سنكلير الى ان بعض المرضى يحتاجون لاختبار قصير لقياس استجابتهم للمثبطات، مشيرا الى ان عدم ظهور تحسن مبكر لا يعني فشل العلاج، ومؤكدا ان علاج الثعلبه يحتاج وقتا للتكيف مع التغيرات المناعيه داخل البصيله، وهو ما يجعل الاستمرار اساسيا قبل الحكم على البروتوكول.
خطوات التقييم الاولي قبل بدء علاج الثعلبه
تحتاج حالات الثعلبه لتقييم شامل قبل بدء العلاج لتحديد عمق الالتهاب وقدره البصيله على الاستجابه، ويشمل هذا التقييم فحص فروه الراس، تصوير بصري للبصيلات، وتحديد المناطق الاكثر تضررا، ويؤكد الخبراء ان تحديد هذه المعايير يساعد على بناء خطه علاجيه دقيقه تعتمد على المثبطات والبلازما الغنيه بالصفائح.
وقال سنكلير ان التقييم يشكل حجر الاساس في علاج الثعلبه، موضحا ان بعض المرضى قد يبدون مؤهلين للبلازما بينما يكون الالتهاب لديهم اكثر عمقا مما يجعل المثبطات الخيار الاول، ومضيفا ان الدمج العلاجي يجب ان يعتمد على تحليل دقيق لا يتجاوز اي مرحله من مراحل التشخيص.
واكد شابيرو ان التصوير الضوئي للبصيله يمثل واحدا من اهم الادوات في فهم مسار المرض، مبينا ان الثعلبه لا تكون دائما ظاهره على السطح، وموضحا ان الفحص الدقيق يمكن ان يكشف عن بقع صغيره خفيه تحتاج الى تدخل مبكر قبل فقدان الشعر بشكل اكبر يصعب علاجه لاحقا.
ونوه سنكلير الى ان بعض المرضى يعانون من نمط سريع التطور من الثعلبه، مشيرا الى ان هذه الفئه تحتاج إلى بروتوكول مكثف يعتمد على المثبطات بشكل رئيسي مع جلسات بلازما متتابعه، ومؤكدا ان تاخير العلاج في هذا النمط يقلل فرص الاستجابه ويفتح المجال لحدوث تساقط اوسع.
الجرعات المثاليه للمثبطات ومده العلاج
تختلف جرعات المثبطات حسب نوع الثعلبه وشده الالتهاب المناعي، وقد اظهرت التجارب السريريهوبحوث سنكلير وشابيرو ان الجرعات تحتاج الى تعديل مستمر حسب الاستجابه، ويؤكد الخبراء ان علاج الثعلبه عبر المثبطات ليس ثابتا بل يتطور مع الوقت ويخضع لمراقبه دقيقه.
وقال سنكلير ان الجرعات المبكره تهدف لوقف تساقط الشعر، موضحا ان هذه المرحله تستغرق بين شهرين وثلاثه اشهر، ومضيفا ان الانتقال لمرحله دعم نمو الشعر يحتاج جرعات متوازنه ومتدرجه، ومؤكدا ان السر يكمن في عدم الانقطاع المفاجئ الذي قد يعيد نشاط المناعه.
واكد شابيرو ان المثبطات تحتاج خطه زمنيهوقد تستمر لمده عام كامل في حالات الثعلبه الشديده، مبينا ان خفض الجرعه قبل الوقت المناسب قد يؤدي لانتكاس، وموضحا ان تثبيت البصيله يحتاج فتره طويله حتى تستعيد دورتها الطبيعيه بالكامل خصوصا في حالات فقدان الشعر الواسع.
ونوه سنكلير الى ان بعض المرضى يستجيبون بشكل اسرع، مشيرا الى ان ذلك لا يعني امكانيه ايقاف المثبطات مبكرا، ومؤكدا ان الحفاظ على النتيجه يحتاج فتره تثبيت تتراوح بين اربعه الى ستة اشهر، وهو ما يجعل التزام المريض شرطا اساسيا لنجاح علاج الثعلبه.
تاثير البلازما الغنيه بالصفائح على تسريع نمو الشعر
تلعب البلازما الغنيه بالصفائح دورا مهما في تسريع الاستجابه العلاجيه خصوصا عندما تستخدم مع المثبطات، وقد اكدت دراسه ديرماتولوجيك سيرجري لعام ٢٠١٨ ان البلازما ترفع معدلات الكثافه خلال اسابيع قليله، وتقدم دعما بنيويا يعيد للبصيله قوتها ومقاومتها للعوامل الضاره.
وقال سنكلير ان البلازما تعمل على خطوتين اساسيتين، موضحا انها تنشط الخلايا الجذعيه داخل البصيله وتزيد تدفق الدم في محيطها، ومضيفا ان هذا التاثير يعطي دفعه حقيقيه لنتائج علاج الثعلبه، خصوصا عندما تكون البصيله في مرحله مبكره من التعافي بعد استخدام المثبطات.
واكد شابيرو ان جلسه واحده من البلازما لا تكفي لاحداث تغيير واضح، مبينا ان البناء التراكمي للجلسات هو ما يحقق الفرق، وموضحا ان الحالات التي تتلقى جلسات منتظمه كل ثلاثه الى اربعه اسابيع تحصد نتائج افضل بكثير من المرضى الذين يخضعون لجلسات متباعده غير منتظمه.
ونوه سنكلير الى ان البلازما ليست بديلا عن المثبطات، مشيرا الى ان علاج الثعلبه يتطلب توازنا دقيقا بين العلاج المناعي والعلاج الحيوي، ومؤكدا ان الاعتماد على البلازما فقط قد ينجح في حالات خفيفه لكنه لا يناسب الحالات التي تعاني من التهاب عميق او نشاط مناعي مرتفع.
استراتيجيات منع الانتكاس بعد علاج الثعلبه
يعاني كثير من المرضى من عوده الثعلبه بعد ايقاف العلاج، ويشير الخبراء الى ان الانتكاس يرتبط بعوده النشاط المناعي، مما يجعل مرحله الصيانه جزءا اساسيا من علاج الثعلبه، وتحتاج هذه المرحله لجدول دقيق يعتمد على تخفيض الجرعات واستمرار جلسات البلازما الغنيه بالصفائح.
وقال سنكلير ان الانتكاس ليس دليلا على فشل العلاج، موضحا ان الثعلبه مرض مناعي متقلب، ومضيفا ان المرحله الوقائيه بعد العلاج اساس مهم للحفاظ على النتيجه، ومؤكدا ان المرضى الذين يواصلون جلسات البلازما بشكل دوري يحافظون على نتائجهم لفترات اطول.
واكد شابيرو ان الصيانه المناعيه عبر جرعات منخفضه من المثبطات قد تمنع عوده الالتهاب داخل البصيله، مبينا ان الهدف ليس الاستمرار بجرعات علاجيه عاليه، بل الحفاظ على مستوى مستقر يمنع المناعه من مهاجمه البصيله مره اخرى، وموضحا ان هذا النهج اصبح معيارا عالميا في علاج الثعلبه.
ونوه سنكلير الى ان بعض المرضى يحتاجون خطه صيانهوتمتد من عام الى عامين حسب طبيعه الثعلبه لديهم، مشيرا الى ان الحالات التي تعاني انتكاسات متكرره تحتاج مراقبه اقرب وجلسات بلازما اكثر انتظاما، ومؤكدا ان المحافظه على سماكه الشعر خلال هذه الفتره تعد مؤشرا لنجاح العلاج.
دوره العوامل الوراثيه في تحديد استجابه علاج الثعلبه
كشفت دراسه ديرماتولوجي اندوكرينولوجي ٢٠٢٠ ان العوامل الوراثيه تحدد جزءا كبيرا من استجابه المريض للعلاج، حيث تلعب بعض الجينات دورا في تنظيم المسار المناعي للبصيله، ما يجعل استجابه المثبطات متفاوته بين مريض واخر، وهو ما يؤثر على خطط علاج الثعلبه.
وقال سنكلير ان العوامل الوراثيه لا تعني ان العلاج غير مجد، موضحا ان فهم الطفرات المناعيه يساعد في بناء بروتوكول اكثر دقه، ومضيفا ان المرضى ذوي النشاط المناعي العالي يحتاجون جرعات اقوى، بينما تستجيب الفئات الاخرى للبلازما الغنيه بالصفائح بشكل اسرع من غيرهم.
واكد شابيرو ان العوامل الوراثيه ليست ثابته في تاثيرها، مبينا ان الدمج العلاجي يقلل اختلاف الاستجابات بين المرضى، وموضحا ان المثبطات تمنح اساسا موحدا عبر كبح المسار المناعي، بينما تقدم البلازما دعما حيويا يرفع فرص النمو رغم اختلاف العوامل الوراثيه.
ونوه سنكلير الى ان التحليل الجيني ليس ضروريا لكل مريض، مشيرا الى ان التشخيص السريري يقدم مؤشرات واضحه على طبيعه الاستجابه، ومؤكدا ان تحسين البروتوكول يعتمد على مراقبه نتائج اول شهرين وتعديل الجرعات والجلسات حسب التحسن الظاهر على فروه الراس.
بروتوكولات التعامل مع الحالات المزمنة
يشير مسار الابحاث العالميه اليوم الى مرحله اكثر نضجا في فهم الثعلبه، خصوصا بعد تراكم البيانات المتعلقه بفاعليه المثبطات والبلازما الغنيه بالصفائح في علاج الثعلبه على المدى الطويل. هذا التراكم العلمي جعل الاطباء يعيدون صياغه بروتوكولات التعامل مع الحالات المزمنه بما يضمن ثبات الاستجابه وعلاج الانتكاسات.
قال خبراء متخصصون في العلاجات المناعيه ان الجمع بين المثبطات والبلازما الغنيه بالصفائح غيّر النظره التقليديه لعلاج الثعلبه، مبينين ان العلاجات القديمه لم تكن تعالج المنشا المناعي للاضطراب بل تركز فقط على تقليل الحلقات الالتهابيه حول بصيله الشعر. واضاف الخبراء ان الدمج اعاد تعريف مفهوم الاستجابه الكامله.
واكد البروفيسور رودني سينكلير ان المتابعه الطويله لمرضى الثعلبه اثبتت ان المثبطات توفر مسارا علاجيا عميقا يوقف الاستهداف المناعي للبصيله، موضحا ان البلازما الغنيه بالصفائح تكمل هذا الدور عبر تسريع تجدد الطبقه الخلويه العميقه داخل الوحده الجريبيه. وذكر سينكلير ان الدمج يحقق معدلات اعلى من الاستدامه.
ونوه الدكتور جيري شابيرو الى ان مناقشات المؤتمرات الاخيره ركزت على الدمج بين النهجين بدل استخدامهما كل على حده، مشيرا الى ان الدراسات الواقعيه اثبتت ان علاج الثعلبه عبر المثبطات فقط قد يفقد بعض قوته بعد سنوات، بينما يمنح الدمج دعما تجديديا يقلل فرص تراجع الكثافه في المستقبل.
دور البروتوكولات المتدرجه في تحسين استجابه الثعلبه
بينت تقارير متخصصه ان البروتوكولات المتدرجه في علاج الثعلبه اصبحت اكثر فعاليه من البروتوكولات الثابته، خصوصا عند استخدام المثبطات بجرعات مرنه تنتقل من التركيز العالي الى المتوسط ثم المنخفض وفقا لاستجابه المريض. واشارت البيانات الى ان هذا النهج يقلل الاعراض الجانبيه ويحافظ على النتيجه.
قال سينكلير ان تطبيق البروتوكولات المتدرجه يسمح بفهم ديناميكيه الثعلبه داخل البصيله، مضيفا ان بعض المرضى يستجيبون سريعا بينما يحتاج اخرون لمدد اطول، ما يتطلب ضبطا مستمرا للجرعه. وذكر ان ارفاق البلازما الغنيه بالصفائح في المراحل المتوسطه يرفع نسب النمو.
واكد باحثون استراليون ان البروتوكولات المتدرجه تقلل ايضا فرص الانتكاس، موضحين ان اعطاء جلسات البلازما الغنيه بالصفائح كل اربع اسابيع لمده اربعه اشهر ساعد في الحفاظ على ثبات الشعر في حالات الثعلبه الواسعه. واضاف الباحثون ان الدمج كان احد اسباب تحسين الدوره الجريبيه.
ونوه شابيرو الى ان الباحثين في الدراسه المنشوره في Journal of Investigative Dermatology تحدثوا عن مفهوم الانتقال التدريجي في جرعات مثبطات JAK، مبينا ان المرضى الذين تلقوا جرعات مرنه سجلوا نتائج استدامه اعلى خلال عام كامل. واشار الى ان هذا المفهوم يعد حاليا من اهم ادوات علاج الثعلبه.
التحديات التي تواجه استدامه النتائج بعد علاج الثعلبه
بين متخصصون في طب الشعر ان التحدي الاكبر في علاج الثعلبه هو ضمان بقاء النتائج بعد التوقف التدريجي عن العلاج، حيث تعاني نسبه ليست قليله من المرضى من انخفاض تدريجي في الكثافه بعد اشهر من وقف المثبطات. واعتبر الاطباء ان هذا النمط يمكن تقليله عبر الدعم التجديدي.
قال سينكلير ان البلازما الغنيه بالصفائح تلعب دورا جوهريا في تحسين الاستدامه، موضحا ان عوامل النمو داخل الصفائح تحفز الخلايا الجذعيه في البصيله على البقاء في مرحله النشاط. وذكر ان هذا التاثير يجعل علاج الثعلبه عبر الدمج اكثر ثباتا في الفترات اللاحقه للعلاج.
واكدت البيانات الملحقه بالدراسه المنشوره في JAMA Dermatology ان اداء المثبطات كان افضل عندما ترافق مع تدخلات تحفيزيه مثل البلازما الغنيه بالصفائح، حيث سجل المرضى الذين تلقوا الدمج نسب بقاء اعلى بعد عامين من المتابعه. واشار الباحثون الى انخفاض واضح في حوادث الانتكاس.
ونوه شابيرو الى ان بعض المرضى يحتاجون الى جلسات صيانته ربع سنويه من البلازما الغنيه بالصفائح للحفاظ على نتيجه علاج الثعلبه، مبينا ان هذه الجلسات ليست علاجا مستقلا بل مكمله للدعم المناعي الذي تقدمه المثبطات. وذكر ان هذا النهج اصبح رائجا في العيادات المتخصصه.
فهم التفاعل بين المناعه والتجدد داخل بصيله الشعر
بينت تحليلات بحثيه حديثه ان التفاعل بين المناعه والتجدد داخل بصيله الشعر يمثل حجر الاساس في نجاح علاج الثعلبه، خصوصا ان البصيله تتعرض لهجمات مناعيه متكرره تسبب دخولها في طور السكون. واشارت التحليلات الى ان نقاط التداخل بين العاملين هي التي تحدد النتيجه النهائيه.
قال سينكلير ان المثبطات تتحكم في الجانب المناعي عبر تعطيل المسارات التي تؤدي الى اطلاق السايتوكاينات، مضيفا ان تعطيل هذه المسارات يسمح للبصيله بالعودة تدريجيا الى حالتها الطبيعيه. وذكر ان هذا الجانب لا يكفي وحده ما لم يتم دعمه بتحفيز تجديدي.
واكد شابيرو ان البلازما الغنيه بالصفائح توفر هذا التحفيز، موضحا ان عوامل النمو المحمله داخل الصفائح تعيد تنشيط البصيله وتزيد من تدفق الدم الدقيق حولها، ما يفسر قدرتها على تحسين نتائج علاج الثعلبه عند دمجها بالمثبطات. وذكر ان هذا التفاعل هو ما يحسن مرونه البصيله.
ونوه باحثون في جامعه كولومبيا الى ان الدراسات اظهرت ان الدمج بين النهجين عزز الانتقال من طور السكون الى طور النمو بنسبه اعلى من استخدام اي منهما منفردا، مشيرين الى ان هذا التاثير المزدوج يوفر توازنا بين المناعه والتجدد. واشار الباحثون الى ان ذلك شكل تطورا مهما في فهم علاج الثعلبه.
بناء خطط طويله الامد للسيطره على الثعلبه المزمنه
بين اطباء متخصصون في العلاج طويل الامد ان الثعلبه المزمنه تحتاج الى خطط تتجاوز العلاج الاول وتصل الى مرحله الحفاظ على النتيجه، مؤكدين ان هذه الخطط تختلف من مريض لاخر وفق تاريخ الحاله. واعتبر الاطباء ان الاعتماد على المثبطات فقط لم يعد كافيا للحالات الممتده.
قال سينكلير ان نجاح علاج الثعلبه على المدى الطويل يتطلب اعاده هيكله البروتوكول كل ست اشهر وفقا لاستجابه المريض، مضيفا ان ادماج جلسات البلازما الغنيه بالصفائح في مراحل محدده يمثل محور هذه الخطط. وذكر ان التعديل المستمر يمنع تراجع النتيجه.
واكد شابيرو ان السنوات الاخيره اثبتت ان الدعم التجديدي لا يقل اهميه عن الدعم المناعي، مبينا ان البلازما الغنيه بالصفائح اصبحت جزءا ثابتا في بروتوكولات علاج الثعلبه في مراكز العالم المتقدم. واشار الى ان الدمج يمنح البصيله قدرتها الطبيعيه على الثبات.
ونوهت فرق بحث امريكيه الى ان الجمع بين التحكم المناعي والصيانه التجديديه شكل منهجا متكاملا سمح بتقليل نسب الانتكاس السنوي بنحو لافت، وذكرت التقارير ان هذا التغيير رفع مستوى الرضا لدى المرضى الذين عانوا من الثعلبه لفترات تفوق خمس سنوات قبل العلاج.
خلاصة ختاميّة لمسار العلاجات الحديثه للثعلبه
بينت التجارب الدوليه خلال العقد الاخير ان علاج الثعلبه تطور بشكل جذري مع ظهور المثبطات والبلازما الغنيه بالصفائح، حيث اصبح العلاج يستند الى علم اكبر وفهم اعمق لديناميكيه المناعه والتجدد. ومع هذا التطور باتت الثعلبه حاله يمكن التعامل معها بفاعليه عاليه.
قال سينكلير ان المثبطات كانت نقطه التحول الاولى في علاج الثعلبه، مضيفا ان الدمج مع البلازما الغنيه بالصفائح شكل التحول الثاني الذي اعاد الامل للمرضى. وذكر ان النتائج المتدرجه اكدت ان الدمج هو الطريق الاكثر ثباتا للحالات المزمنه.
واكد شابيرو ان المستقبل يتجه نحو بروتوكولات اكثر دقه تجمع بين العوامل المناعيه والعوامل التجديديه، مبينا ان الدراسات الحقيقيه التي ناقشت علاج الثعلبه اثبتت ان الدمج يعزز الكثافه ويحسن الاستدامه. واشار الى ان هذا المسار سيظل محور الابحاث العالميه.
ونوهت الفرق البحثيه التي شاركت في دراستي Journal of Investigative Dermatology وJAMA Dermatology الى ان البيانات التي تم جمعها عززت مفهوم العلاجات المزدوجه، وذكرت ان هذا المفهوم قد يغير شكل علاج الثعلبه خلال السنوات المقبله، ويقدم طريقا اكثر ثباتا وانسجاما مع طبيعه البصيله وجهاز المناعه.
المصادر العلمية
دراسات المثبطات JAK Inhibitors
JAK inhibitors for alopecia areata: A systematic review and meta analysis
JAMA Network Open – 2023
تحليل تلوي واسع شمل تجارب سريرية عشوائية، وتناول فاعلية مثبطات JAK في علاج الثعلبه.
The evaluation of JAK inhibitors on effect and safety in alopecia areata: a systematic review and meta analysis
Frontiers in Pharmacology – 2023
مراجعة شاملة لسلامة وفعالية مثبطات JAK في حالات الثعلبه المتوسطة والشديدة.
دراسات البلازما الغنية بالصفائح PRP
Platelet-Rich Plasma in the Management of Alopecia: A Systematic Review and Meta-Analysis
Dermatologic Surgery – 2024
تحليل تلوي تناول فاعلية PRP في تحسين كثافة الشعر وتقليل التساقط في أنواع مختلفه من الثعلبه.
Platelet-rich plasma in alopecia areata and primary cicatricial alopecias: A systematic review
Journal of the American Academy of Dermatology – 2023
مراجعة تتناول PRP كخيار علاجي في الثعلبه المناعية، مع توضيح جودة الأدلة المتاحة.
دراسات آليات وتأثير PRP
Platelet-Rich Plasma (PRP) in Dermatology: Cellular and Molecular Mechanisms of Action
International Journal of Molecular Sciences – 2024
ورقة بحثية تفصل الآليات الخلوية والجزيئية التي تعزز بها PRP نمو الشعر.
Efficacy of Platelet-Rich Plasma in Alopecia: A Meta-Analysis with Methodologic Review
Journal of Cosmetic Dermatology – 2022
مراجعة تحليلية تناقش تباين بروتوكولات PRP وتأثير ذلك على النتائج.
دراسات مقارنة بين العلاجات
Combination therapy in alopecia areata: PRP with medical therapy
Journal of Dermatological Treatment – 2022
دراسة تبحث في نتيجة الجمع بين PRP والعلاجات الدوائية التقليدية.
Comparative evaluation of PRP and topical treatments in alopecia areata
Dermatologic Therapy – 2023
دراسة تقارن فاعلية PRP مقابل العلاجات الموضعية التقليدية.
خبراء عالميون مستخدمون في التقرير
Professor Rodney Sinclair
خبير عالمي في علاج حالات الثعلبه وامراض الشعر – جامعة ملبورن – استراليا.
له عشرات الاوراق العلمية حول Alopecia وDermatology Therapeutics.
Professor Jerry Shapiro
متخصص عالمي في طب الشعر – جامعة نيويورك – الولايات المتحدة.
احد اكثر الباحثين نشرا في alopecia areata وscarring alopecia.
مراجع إضافية داعمة
Alopecia Areata Clinical Guidelines
American Academy of Dermatology – AAD
ارشادات علمية ومعتمدة حديثا حول خيارات علاج الثعلبه.
Pathogenesis of Alopecia Areata
Nature Reviews Disease Primers – 2022
مرجع مهم حول فهم المناعة الذاتية المؤدية للثعلبه.